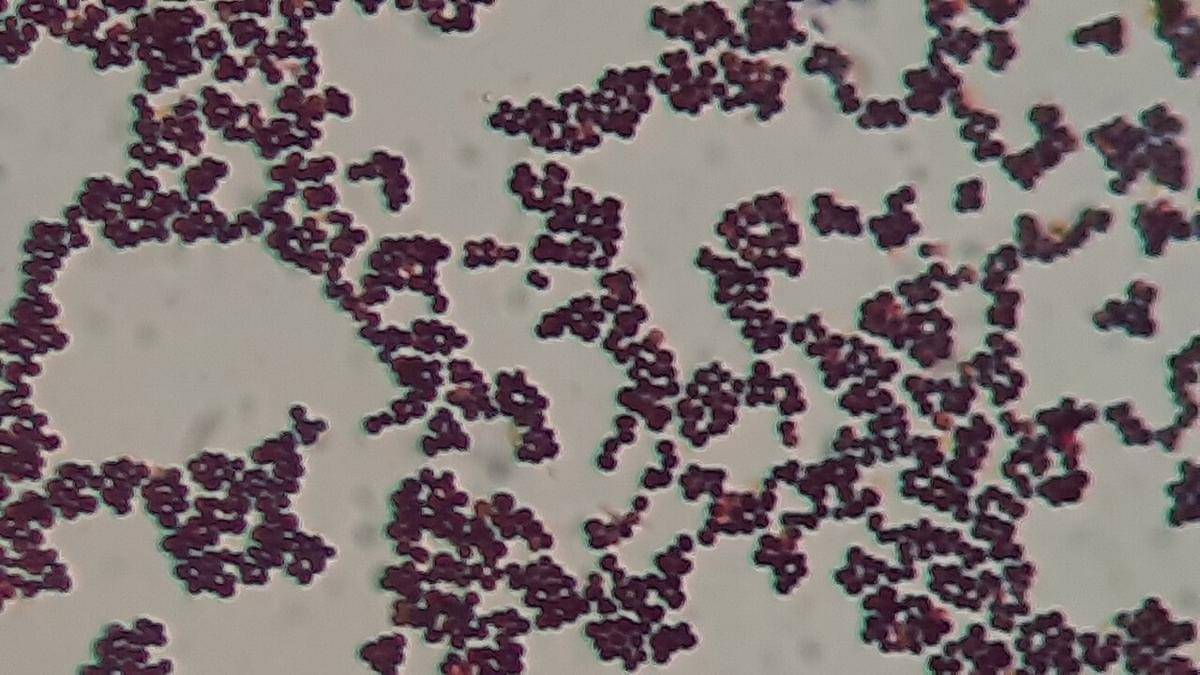

"When the heat… smells" Exden. Diakses pada Oktober 2025.
"The science behind the stink of spring and summer." Ecosorb. Diakses pada Oktober 2025.
"How Body Odor Can Indicate Health Changes" Baptist Health. Diakses pada Oktober 2025.
"Beat the Heat: Tips for Managing Sweating and Body Odour" Novus Health. Diakses pada Oktober 2025.
Kenapa Bau Badan Jadi Lebih Tajam saat Cuaca Panas?

Ketika cuaca panas datang, tubuh tidak hanya terasa gerah, tapi juga sering mengeluarkan aroma yang lebih kuat dari biasanya. Banyak orang menganggap hal ini sebagai tanda kalau kita kurang menjaga kebersihan diri, padahal ada penjelasan di baliknya. Tubuh manusia punya cara tersendiri dalam beradaptasi terhadap suhu tinggi, dan salah satunya melalui mekanisme keringat.
Perubahan kecil ini ternyata berhubungan erat dengan sistem metabolisme hingga gaya hidup sehari-hari. Semua faktor itu bisa saling memengaruhi hingga akhirnya memunculkan bau badan yang lebih tajam. Berikut beberapa penjelasan yang bisa membantu memahami kenapa tubuh bereaksi seperti itu saat suhu mulai meningkat.
1. Tubuh mengeluarkan lebih banyak keringat untuk menstabilkan suhu

Saat suhu lingkungan naik, sistem termoregulasi tubuh (kemampuan untuk menjaga keseimbangan antara pembentukan panas dan kehilangan panas agar dapat mempertahankan suhu tubuh di dalam batas batas normal) bekerja lebih keras untuk menjaga suhu inti tetap stabil. Salah satu caranya adalah dengan mengeluarkan keringat lewat kelenjar ekrin di seluruh permukaan kulit. Cairan ini sebagian besar mengandung air dan elektrolit, namun ketika bercampur dengan bakteri alami kulit, akan terbentuk senyawa yang menimbulkan aroma khas. Proses inilah yang membuat bau badan lebih terasa saat cuaca sedang panas.
Menariknya, jumlah keringat yang dihasilkan setiap orang berbeda tergantung faktor genetik, hormon, dan kebiasaan fisik. Mereka yang aktif beraktivitas atau memiliki metabolisme cepat cenderung berkeringat lebih banyak. Akibatnya, peluang timbulnya bau badan juga lebih tinggi. Jadi, meningkatnya aroma tubuh bukan tanda penyakit, melainkan respon alami tubuh dalam menghadapi panas ekstrem.
2. Aktivitas bakteri kulit meningkat akibat lingkungan lembap
Kulit manusia merupakan rumah bagi jutaan mikroorganisme, termasuk bakteri yang berperan dalam menjaga keseimbangan alami kulit. Saat cuaca panas, kondisi kulit menjadi lebih lembap karena keringat yang menumpuk di permukaan. Lingkungan lembap dan hangat ini mempercepat pertumbuhan bakteri seperti Corynebacterium atau Staphylococcus hominis, yang memecah protein dan asam lemak dalam keringat menjadi senyawa berbau tajam.
Proses ini adalah penyebab utama kenapa bau badan terasa lebih menyengat dibanding hari-hari sejuk. Bukan karena tubuh kotor, melainkan karena aktivitas bakteri meningkat secara signifikan. Oleh sebab itu, menjaga kebersihan kulit dengan cara mandi dua kali sehari dan mengganti pakaian berkeringat menjadi langkah sederhana namun efektif untuk mengendalikan aroma tubuh.
3. Hormon dan stres ikut memicu perubahan aroma tubuh

Bau badan tidak selalu muncul karena suhu tinggi semata, tapi juga dipengaruhi oleh faktor internal seperti stres dan perubahan hormon. Ketika seseorang merasa cemas, sistem saraf simpatis memicu kelenjar apokrin yakni jenis kelenjar keringat yang banyak terdapat di ketiak dan area sensitif. Keringat dari kelenjar ini mengandung lemak dan protein, yang saat bereaksi dengan bakteri akan menghasilkan aroma lebih kuat daripada keringat biasa.
Cuaca panas bisa memperparah efek ini karena tubuh sudah berada dalam kondisi “tertekan” oleh suhu tinggi. Kombinasi antara stres fisik dan emosional membuat kelenjar apokrin bekerja lebih aktif. Itulah mengapa seseorang bisa mengeluarkan aroma tubuh yang lebih menyengat saat sedang gugup atau lelah di hari panas, meski sudah mandi sebelumnya.
4. Pola makan memengaruhi komposisi keringat

Apa yang dikonsumsi seseorang ternyata juga menentukan seberapa tajam aroma tubuhnya saat suhu naik. Makanan seperti bawang, daging merah, dan makanan tinggi sulfur dapat mengubah bau alami tubuh karena zat kimia di dalamnya ikut keluar lewat keringat. Saat cuaca panas, proses metabolisme tubuh meningkat sehingga penguraian zat tersebut berlangsung lebih cepat. Akibatnya, senyawa beraroma tajam lebih cepat mencapai permukaan kulit.
Sebaliknya, pola makan tinggi serat, buah, dan sayur membantu menjaga keseimbangan pH tubuh serta memperlambat produksi senyawa penyebab bau. Air putih juga berperan penting karena membantu proses detoksifikasi alami tubuh. Jadi, memperhatikan apa yang dikonsumsi bukan hanya baik untuk kesehatan pencernaan, tapi juga membantu tubuh tetap segar di suhu ekstrem.
5. Pakaian dan kebiasaan sehari-hari turut menentukan intensitas bau

Kebiasaan sederhana seperti memilih bahan pakaian ternyata punya dampak besar terhadap aroma tubuh. Pakaian berbahan sintetis seperti polyester cenderung menahan panas dan keringat di dalam serat kain, menciptakan tempat ideal bagi bakteri tumbuh. Sementara itu, bahan seperti katun atau linen memberi ruang udara bagi kulit untuk “bernapas”, sehingga keringat bisa cepat menguap dan mengurangi bau.
Selain bahan pakaian, rutinitas harian juga penting diperhatikan. Misalnya, langsung mengganti baju setelah beraktivitas, mengeringkan tubuh dengan baik, dan menggunakan deodoran antiperspiran. Langkah-langkah sederhana ini bukan untuk menutupi bau, melainkan membantu menjaga keseimbangan alami kulit agar tetap sehat dan segar meski cuaca sedang terik.
Cuaca panas memang dapat memperkuat aroma tubuh, tapi penyebabnya jauh lebih kompleks daripada sekadar keringat. Dari aktivitas bakteri hingga reaksi hormon, semua memiliki peran dalam menentukan bagaimana tubuh beradaptasi terhadap suhu tinggi. Dengan memahami proses tersebut, kita bisa lebih bijak menjaga kebersihan dan pola hidup agar tetap nyaman. Jadi, apakah kamu sudah menemukan cara terbaik untuk tetap segar di tengah panas yang menyengat?
Referensi


















